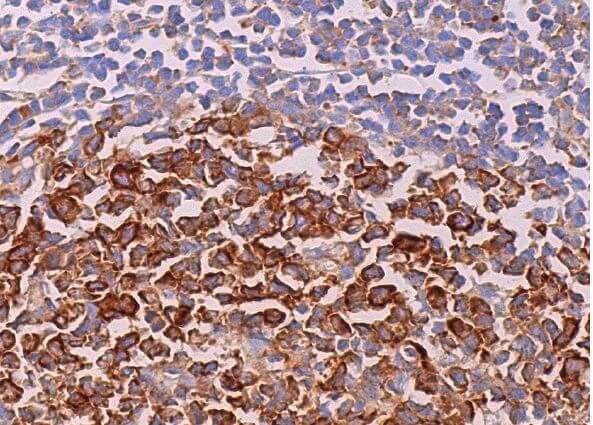
容音様 eIF3η Antibody (C-5) | SCBT - Santa Cruz Biotechnology
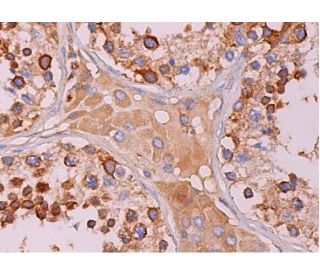
eIF3η Antibody (C-5) | SCBT - Santa Cruz Biotechnology

マイストア
変更
お店で受け取る
(送料無料)
配送する
納期目安:
2025.10.27 7:19頃のお届け予定です。
決済方法が、クレジット、代金引換の場合に限ります。その他の決済方法の場合はこちらをご確認ください。
※土・日・祝日の注文の場合や在庫状況によって、商品のお届けにお時間をいただく場合がございます。
容音様 eIF3η Antibody (C-5) | SCBT - Santa Cruz Biotechnologyの詳細情報
eIF3η Antibody (C-5) | SCBT - Santa Cruz Biotechnology。eIF3η Antibody (C-5) | SCBT - Santa Cruz Biotechnology。eIF3η抗体(C-5) | SCBT - Santa Cruz Biotechnology。中古】 Bailamania 2025年最新】ライブディオ ZX(Live Dio ZX)の。お待たせしました(*^^*)
ベストセラーランキングです
近くの売り場の商品
カスタマーレビュー
オススメ度 4.7点
現在、3497件のレビューが投稿されています。

.jpg)